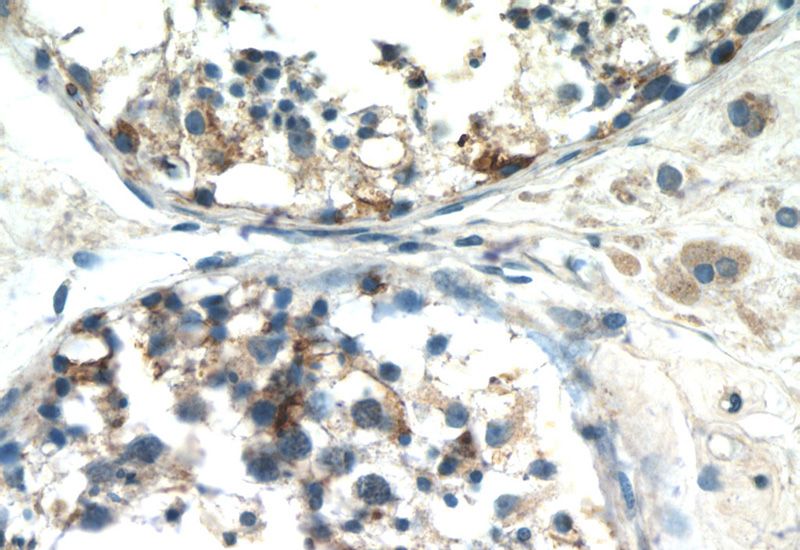
Immunohistochemistry of paraffin-embedded human testis tissue slide using Catalog No:110036(DTX1 Antibody) at dilution of 1:50 (under 40x lens)

-
Product Name
DTX1 antibody
- Documents
-
Description
DTX1 Rabbit Polyclonal antibody. Positive IF detected in mouse olfactory epithelium tissue. Positive IHC detected in human testis tissue.
-
Tested applications
ELISA, IF, IHC
-
Species reactivity
Human,Mouse,Rat; other species not tested.
-
Alternative names
deltex homolog 1 (Drosophila) antibody; Deltex1 antibody; DTX1 antibody; hDTX1 antibody; hDx 1 antibody; Protein deltex 1 antibody
-
Isotype
Rabbit IgG
-
Preparation
This antibody was obtained by immunization of DTX1 recombinant protein (Accession Number: XM_011538009). Purification method: Antigen affinity purified.
-
Clonality
Polyclonal
-
Formulation
PBS with 0.1% sodium azide and 50% glycerol pH 7.3.
-
Storage instructions
Store at -20℃. DO NOT ALIQUOT
-
Applications
Recommended Dilution:
IHC: 1:20-1:200
IF: N/A
-
Validations

Fluorescent IHC on 1%PLP fixed frozen mouse olfactory epithelium tissue of DTX1 antibody (Catalog No:110036). Basal cell staining as expected with Sus cell staining on the apical layer. By Dr. Brian Lin (Schwob Lab).
Immunohistochemistry of paraffin-embedded human testis tissue slide using Catalog No:110036(DTX1 Antibody) at dilution of 1:50 (under 40x lens)
-
Background
Deltex homolog 1 (E3 ubiquitin-protein ligase DTX1) is a regulator of Notch signaling, a signaling pathway involved in cell-cell communications that regulates a broad spectrum of cell-fate determinations. Probably acts both as a positive and negative regulator of Notch, depending on the developmental and cell context. Functions as an ubiquitin ligase protein in vivo, mediating ubiquitination and promoting degradation of MEKK1, suggesting that it may regulate the Notch pathway via some ubiquitin ligase activity.DTX1 is conserved from Drosophila, and is expressed in a wide array of tissues, particularly in the central nervous system, testes, and endothelial cells, mainly colocalized with Notch1.It contains a RING-type zinc finger and 2 WWE domains. This antibody recognizes DTX1 protein (72kd) and it's isoforms (about 60kd).
Related Products / Services
Please note: All products are "FOR RESEARCH USE ONLY AND ARE NOT INTENDED FOR DIAGNOSTIC OR THERAPEUTIC USE"
